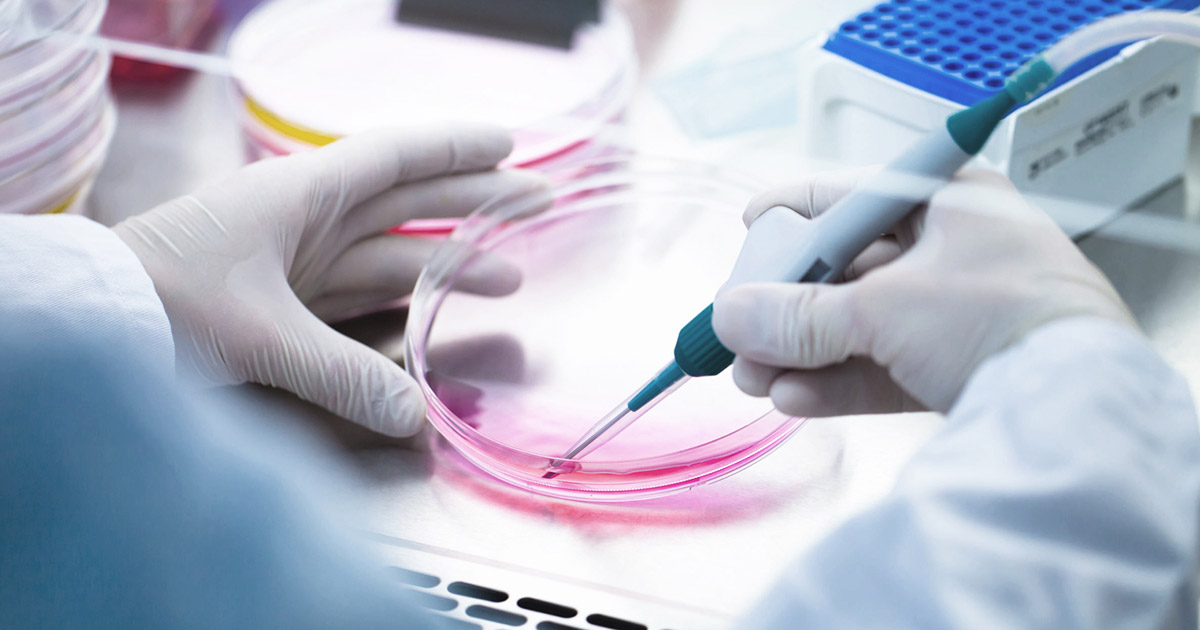
Humanimales | Japón autoriza la creación de órganos humanos en ...

Los “humanimales” o quimeras de la antigua Grecia eran híbridos entre humanos y animales.
Según la mitología, eran monstruos con vientre de cabra y cola de dragón, capaces de lanzar fuego por las fauces de su cabeza de león.
Un grupo de Izpisúa, repartido entre el Instituto Salk de EE.UU. y la UCAM, logró modificar genéticamente embriones de mono para inactivar genes esenciales para la formación de sus órganos. Los científicos inyectaron células humanas capaces de generar cualquier tipo de tejido.
Según informó Estrella Núñez, bióloga y vicerrectora de investigación de la Universidad Católica de Murcia (UCAM), el equipo del investigador Juan Carlos Izpisúa logró de esta forma un gran avance hacia su objetivo final, que es el de convertir animales de otras especies en fábricas de órganos para trasplantes.
El avance español se parece a un gran avance tecnológico que confirmó el gobierno japonés en marzo, cuando permitió que el científico Hiromitsu Nakauchi comenzara a desarrollar órganos humanos en animales a raíz de células madre humanas.
La principal diferencia entre los trabajos españoles y los de Japón consisten en que el país asiático es el primero en el cual el Gobierno avanzó en la idea de avalar oficialmente el desarrollo de la tecnología.
El investigador nipón, Hiromitsu Nakauchi afirmó que el cambio ya le permite avanzar en sus investigaciones, cuyo objetivo final es producir órganos humanos, para que estos puedan ser trasplantados de un animal a una persona.
Deja tu opinión sobre el caso, y comparte este novedoso estudio con tus amigos.